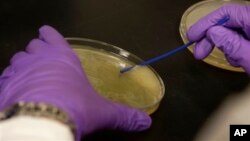
科学家为包括礼来在内的制药公司做实验

美国制药企业礼来公司前高级经理王玮日前对中国“21世纪经济报道”透露,礼来公司为扩大在中国市场的两项胰岛素主推产品,花费3千多万元贿赂医生。王玮说,为了阻击对手的竞争并安插本公司的产品,各种常规贿赂、专款专拨的情况在公司非常普遍,情况之严重丝毫不逊于英国葛兰素史克案。
礼来公司创建于1876年,是全球十大制药企业之一。礼来在华投资超过20亿元人民币,礼来中国是礼来集团第二大分支机构。据报道,目前中国糖尿病药品市场是丹麦诺和、美国礼来和法国赛诺菲三分天下。礼来前高级经理王玮说,礼来主要是跟诺和抢市场,通过给医生回扣这种贿赂手段突破市场份额。他说,“这样的手段通常都被做得很隐蔽,表面上搞得很合规,但内行人都知道是些虚招。”
中国制药行业腐败现象严重。面对公众对医药价格虚高日益不满,中国国家工商管理总局上星期说,将开始对医药行业的行贿受贿现象进行为期三个月的调查。礼来公司是继英国葛兰素史克、法国赛诺菲和瑞士诺华之后,近期内第四家爆发行贿丑闻的在华跨国制药企业。
礼来中国8月21日在给“21世纪经济报道”记者的声明回函中表示:“礼来制药对所提及的这些情况高度重视。这些情况,如果属实,与礼来的价值观、相关政策以及对于全体员工一再强调的合规要求是完全不符的。”
礼来公司通过电邮告诉路透社,“尽管我们尚不能证实这些指控,但我们会认真对待,并正在继续进行调查。”
礼来公司创建于1876年,是全球十大制药企业之一。礼来在华投资超过20亿元人民币,礼来中国是礼来集团第二大分支机构。据报道,目前中国糖尿病药品市场是丹麦诺和、美国礼来和法国赛诺菲三分天下。礼来前高级经理王玮说,礼来主要是跟诺和抢市场,通过给医生回扣这种贿赂手段突破市场份额。他说,“这样的手段通常都被做得很隐蔽,表面上搞得很合规,但内行人都知道是些虚招。”
中国制药行业腐败现象严重。面对公众对医药价格虚高日益不满,中国国家工商管理总局上星期说,将开始对医药行业的行贿受贿现象进行为期三个月的调查。礼来公司是继英国葛兰素史克、法国赛诺菲和瑞士诺华之后,近期内第四家爆发行贿丑闻的在华跨国制药企业。
礼来中国8月21日在给“21世纪经济报道”记者的声明回函中表示:“礼来制药对所提及的这些情况高度重视。这些情况,如果属实,与礼来的价值观、相关政策以及对于全体员工一再强调的合规要求是完全不符的。”
礼来公司通过电邮告诉路透社,“尽管我们尚不能证实这些指控,但我们会认真对待,并正在继续进行调查。”